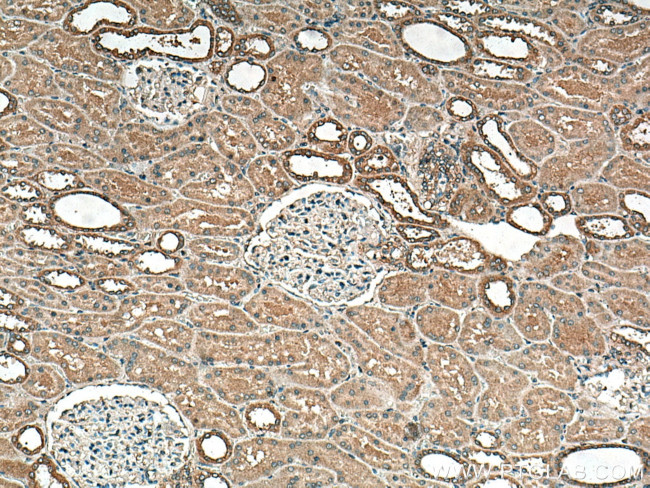
DISP1 Antibody in Immunohistochemistry (Paraffin) (IHC (P))
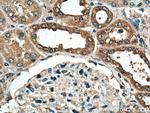
DISP1 Antibody in Immunohistochemistry (Paraffin) (IHC (P))

Search
Proteintech
DISP1 Polyclonal Antibody
{{$productOrderCtrl.translations['antibody.pdp.commerceCard.promotion.promotions']}}
{{$productOrderCtrl.translations['antibody.pdp.commerceCard.promotion.viewpromo']}}
{{$productOrderCtrl.translations['antibody.pdp.commerceCard.promotion.promocode']}}: {{promo.promoCode}} {{promo.promoTitle}} {{promo.promoDescription}}. {{$productOrderCtrl.translations['antibody.pdp.commerceCard.promotion.learnmore']}}
产品信息
12041-1-AP
种属反应
宿主/亚型
分类
类型
抗原
偶联物
形式
浓度
规格
纯化类型
保存液
内含物
保存条件
运输条件
产品详细信息
Immunogen sequence: AYHLDPRGP KSELEHEFYE LEPLASHSCT APEKTTYEET HICSEFFNSQ AKNLGMPVHA AYNSELSKST ESDAGSALLQ PPLEQHTVCH FFSLNQRCSC PDAYKHLNYG PHSCQQMGDC LCHQCSPTTS SFVQIQNGVA PLKATHQAVE GFVHPITHIH HCPCLQGRVK PAGMQNSLPR NFFLHPVQHI QAQEKIGKTN VHSLQRSIEE HLPKMAEPSS FVCRSTGSLL KTCCNPENKQ RELCKNRDVS NLESSGGTEN KAGGKVELSL SQTDASVNSE HFNQNEPKVL FNHLMGEAGC RSCPNNSQSC GRIVRVKCNS VDCQMPNMEA NVPAVLTHSE LSGESLLIKT L (662-1011 aa encoded by BC011542)
靶标信息
The pattern of cellular proliferation and differentiation that leads to normal development of embryonic structures often depends upon the localized production of secreted protein signals. Cells surrounding the source of a particular signal respond in a graded manner according to the effective concentration of the signal, and this response produces the pattern of cell types constituting the mature structure. A novel segment-polarity gene known as dispatched has been identified in Drosophila and its protein product is required for normal Hedgehog signaling. This gene is one of two human homologs of Drosophila dispatched and, based on sequence identity to its mouse counterpart, the encoded protein may play an essential role in Hh patterning activities in the early embryo.
仅用于科研。不用于诊断过程。未经明确授权不得转售。
篇参考文献 (0)
生物信息学
蛋白别名: dispatched A; DKFZP434I0428; FLJ43740; MGC104180; MGC13130; MGC16796; Protein dispatched homolog 1; unnamed protein product
基因别名: DISP1; DISPA; HPE10
UniProt ID: (Human) Q96F81
Entrez Gene ID: (Human) 84976